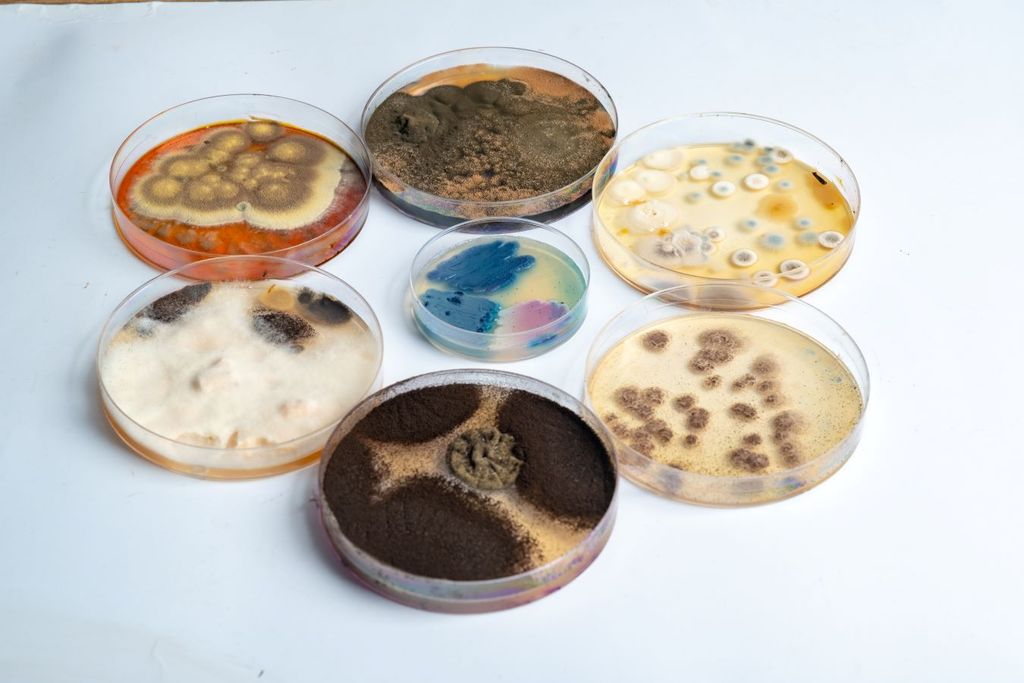
Las micotoxinas son consideradas altamente cancerígenas.

Encienden alertas por almendras contaminadas en la Unión Europea
El Sistema de Alerta Rápida para Alimentos y Piensos de la Unión Europea, informó que se detectó mico toxinas por encima de los niveles permitidos en almendras procedentes de Estados Unidos.

Se encienden las alertas otra vez por alimentos presuntamente contaminados, ahora se trata de almendras procedentes de Estados Unidos y el Sistema de Alerta Rápida para Alimentos y Piensos de la Unión Europea emitió una alerta tras detectar la presencia de aflatoxinas por encima de los niveles permitidos en almendras procedentes de Estados Unidos.
En la notificación se habla de riesgo "serio" al superarse en los análisis realizados el nivel máximo permitido de esta sustancia. Esta toxina está relacionada con un mayor riesgo de padecer algunos tipos de cáncer como el de hígado.
Recuerdas que ya te habíamos informado que investigadores del Centro Universitario de Ciencias Biológicas y Agropecuarias de la Universidad de Guadalajara realizaron a varios estudios para conocer las toxinas que algunos producen durante su crecimiento o análisis como algunas oleaginosas como los cacahuates en México o las almendras, pues sí se encontraron altas concentraciones.
Según explica en su página web, el Servicio de Inocuidad e Inspección de los Alimentos del Departamento de Agricultura de los Estados Unidos, las micotoxinas son sustancias venenosas producidas por algunos hongos que se encuentran mayormente en las siembras de granos y en nueces, en los cacahuates, pistaches, almendras, entre otras, pero también pueden ser encontradas en el apio, jugo de uvas, manzanas y en otras frutas y vegetales.
¿Pero qué son las aflatoxinas?
Las aflatoxinas son micotoxinas producidas por dos especies de Aspergillus, un hongo localizado especialmente en zonas con climas cálidos y húmedos y pueden estar presentes en alimentos como cacahuetes, frutos secos, maíz, arroz, higos y otros alimentos secos, especias, aceites vegetales crudos y granos de cacao, como resultado de la contaminación fúngica antes y después de la cosecha.
La Organización de las Naciones Unidas para la Agricultura y la Alimentación estima que un 25 por ciento de las cosechas a nivel mundial son afectadas por las micotoxinas, de las cuales las aflatoxinas son las más notorias.
Cuando existe una exposición aguda, es decir, consumo de niveles altos de aflatoxinas en un período de algunos días puede presentar dolor abdominal, vómito, hemorragias, falla hepática o falla renal pero cuando existe una exposición crónica se ha asociado a la producción de células cancerígenas.
El riesgo con las oleaginosas son las aflatoxinas sobre todo la B1 que está considerado por la Organización Mundial de la Salud como cancerígena, mutagénica, teratogénica sobre todo en niños recién nacidos y advirtió que no se han encontrado ninguna muestra negativa.
La aflatoxina B1 es el factor que más obstaculiza el desarrollo fetal, con mayor capacidad de provocar o acelerar el cáncer, y es además el tipo de aflatoxina que provoca mayores cambios repentinos y permanentes en los genes, entre estos, puede inducir una mutación específica en el condón relacionado con la génesis de tumores.
Según la OMS, cada año enferman en el mundo alrededor de 600 millones de personas, casi 1 de cada 10 habitantes del planeta, por ingerir alimentos contaminados y 420 mil mueren por esta causa.
Las enfermedades transmitidas por los alimentos son generalmente de carácter infeccioso o tóxico y son causadas por bacterias, hongos, virus, parásitos o sustancias químicas que penetran en el organismo a través del agua o los alimentos contaminados .